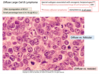

Chapter 13: Common Forms of Lymphoid Leukemia and Lymphoma Flashcards
There is an association with smoking and which neoplastic proliferation of white cells?
Acute myeloid leukemia
Among lymphoid cells, potentially oncogenic mutations occur most frequently where and during what?
Germinal center B cells during attempted antibody diversification
What is CD11c expressed on?
- Granulocytes, monocytes, and macrophages
- Also expressed by hairy cell leukemias
How does the spread of Hodgkin lymphoma differ from that of NHL’s?
- Hodgkin spreads in an orderly fashion
- Most forms of NHL spread widely early in their course and in less predictable fashion
Any child presenting with very low platelet counts has what until proven otherwise?
Acute lymphoblastic leukemia (ALL)
B-ALL is most often associated with what translocation?
t(12;21)
What is the cell of origin for B-ALL?
Bone marrow precursor B cell
90% of ALLs have numerical or structural chromosomal changes; most common is what?
Hyperploidy (>50 chromosomes)
Which immunostaining marker and B-cell markers are positive in B-ALLs?
- (+) for TdT
- Express CD10, CD19, and CD20

A majority of T-ALLs have gain of function mutation in what gene?
NOTCH1
Which CD markers are expressed by the cells of T-ALLs?
CD2 to CD8
Although genetically and immunophenotypically distinct, what are the clinical features shared between ALL and AML?
- Abrupt onset within days to weeks
- Sx’s related to depression of marrow function, fever, infection, bleeding
- Mass effects, including bone pain; generalized LAD, hepatosplenomegaly; testicular enlargement
CNS manifestations such as HA, vomiting, and nerve palsies from meningeal spread are more common in which neoplasia of WBC’s?
ALL

What are 3 factors associated with a worse prognosis of ALL?
- Age <2 y/o
- Presentation in adolescence or young adults
- Peripheral blasts >100,000

What are 5 features of ALL which would be associated with a favorable prognosis?
- Age btw 2-10 y/o
- Low WBC count
- Hyperdiploidy
- Trisomy of chromosomes 4, 7, and 10
- Presence of t(12;22)

What are the most common genetic anomalies associated with CLL/SLL?
Trisomy 12, deletions of 11q, 13q, and 17p
Which distinct CD markers are expressed by the cells of CLL/SLL?
CD19 and CD20, as well as CD5*** and CD23
When present, which finding in the lymph nodes is pathognomonic for CLL/SLL?
Proliferation centers = large lymphocytes gathered in loos aggregates that contain mitotically active cells
What is the absolute lymphocyte count of peripheral blood in CLL that distinguishes it from SLL?
>5000 mm3

Uncommon, nucleated B cells known as prolymphocytes are sometimes seen in the lymph nodes assoc. w/ what neoplasm?
CLL/SLL

What is a characteristic finding on peripheral smear in CLL?
Smudge cells

How does the leukocyte count vary between CLL and SLL?
- CLL can have leukocyte counts in excess of 200,000 m3
- SLL can present have leukopenia with marrow involvement
Most common age group and salient clinical features of CLL/SLL; minority of patients develop what?
- Older adults w/ bone marrow, LN, spleen, and liver disease
- Autoimmune hemolysis and thrombocytopenia in a minority
Which finding due to disruption of normal immune function is common in CLL/SLL?
HYPOgammaglobulinemia which ↑ susceptibility to infections
The presence of which mutated gene is associated with worse outcomes in CLL/SLL?
NOTCH1
Development of a rapidly enlarging mass within a LN or spleen in pt with CLL/SLL is suggestive of what?
Richter syndrome –> prolymphocyte transformation to diffuse large B cell lymphoma = ominous event; survival <1 year
Follicular lymphoma arises from where; what is the hallmark translocation?
- Arise from germinal center B cells
- Hallmark = t(14;18) –> BCL2-IgH fusion gene

Follicular lymphoma most often occurs in what age group and which sex?
Middle aged adults; M=F
Which 4 features of follicular lymphoma distinguish it from reactive follicular hyperplasia?
- Disruption of normal LN architecture
- Lack of tingible body macrophages in germinal centers
- Bcl2 expression in follicles
- Monoclonality
The neoplastic cells of follicular lymphoma express which markers?
- CD19, CD20, CD10; surface Ig, and BCL6
- BCL2 is expressed in 90%
Typical presentation of follicular lymphoma?
- Older adult w/ painless generalized LAD and marrow involement
- Extranodal involvement of GI tract, CNS, or testis = UNCOMMON
What is the typical course and survival like for follicular lymphoma?
- Incurable, usually follows indolent waxing and waning course
- Median survival = 7-9 years
How likely is histologic transformation of follicular lymphoma?
30-50% transform into DLBCL
What is the peripheral blood and bone marrow involvement like in follicular lymphoma; which other sites are commonly involved?
- Peripheral blood may have lymphocytosis (<20,000) in 10%
- Bone marrow involvement characterized by paratrabecular lymphoid aggregates
- Splenic WHITE pulp and hepatic portal triads frequently involved

What are the salient clinical features of diffuse large B-cell lymphoma; which ages?
- All ages, but most common in older adults (median age = 60)
- Often appears as rapidly growing mass at nodal or extranodal site
Diffuse large B-cell lymphoma is associated with what genetic anomalies?
- Dysregulation of BCL6 (essential for normal germinal center formation)
- Small % have t(14;18) - BCL2

Which sites are commonly and uncommonly involved with diffuse large B-cell lymphoma?
- Waldeyer ring, the oropharyngeal lymphoid tissue including tonsils and adenoids = frequently involved
- 1’ or 2’ involvement of spleen and liver = large destructive masses
- Extranodal involvement of GI tract, skin, bone, and brain
- BM involvement = uncommon

How does the subtype of DLBCL, Primary Effusion Lymphoma, typically present and the tumor cells are always infected with what?
- Malignant pleural or ascitic effusion, mostly in pt’s with advaned HIV or older adults
- In all cases the tumor cells infected w/ KSHV/HHV-8

The immunodeficiency-associated large B-cell lymphoma is associated with what infection?
B cells are infected with EBV
Burkitt lymphoma is associated with what translocation; which genes on each chromosome?
t(8;14) = MYC-IgH

Unlike other tumors of germinal B-cell origin, Burkitt lymphome virtually always fails to express what?
The anti-apoptotic protein BCL2
What is the significance of increased MYC levels associated with Burkitt Lymphoma?
↑ genes required for aerobic glycolysis (Warburg effect) allowing cells to biosynthesize all the building blocks needed for cell growth and division

Both endemic and sporadic Burkitt Lymphomas are found mainly in whom and most tumors are found where?
Mainly in children or young adults; most arising at extranodal sites
Which extra-nodal sites do the endemic vs. sporadic form of Burkitt Lymphoma have predilection for?
- Endemic often presents as mass involving the mandible and has unusual predilection for abdominal viscera (kidneys, ovaries, adrenals)
- Sporadic most often appears as mass involving ileocecum and peritoneum
Essentially all Burkitt Lymphomas of which subtype are latently infected with EBV; small percentage of which other subtypes?
- ALL endemic (African) form
- Also 25% of HIV-associated tumors + 15-20% of sporadic cases

The tumor cells of Burkitt Lymphoma will express what?
Mature B cell markers = IgM, CD19, CD20, CD10, and BCL6
Which pattern/morphology is seen in tissues with Burkitt Lymphoma?
- Tumors w/ high mitotic index and numerous apoptotic cells
- Phagocytes w/ abundant clear cytoplasm, creating characteristic “starry sky” pattern

Typical behavior of Burkitt Lymphoma; response to treatment?
- Very aggressive but responds well to intensive chemotherapy
- Most children/young adults can be cured
- Outcome is more guarded in older adults